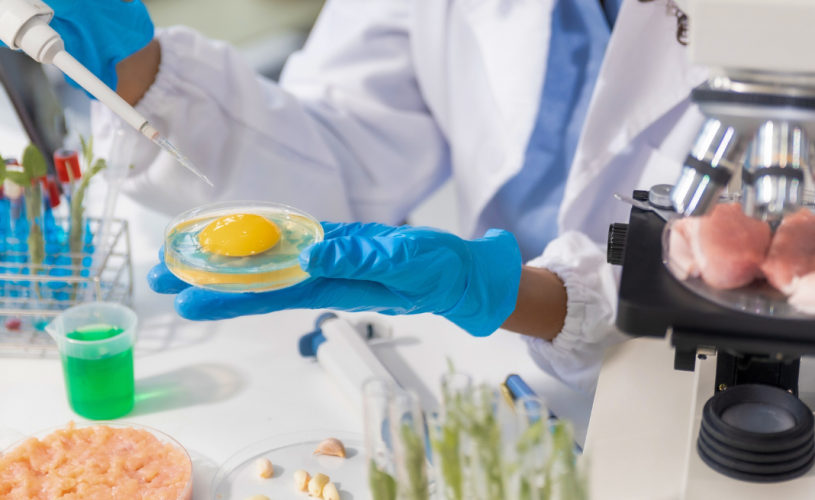

Home » Novidades na saúde
Novidades na saúde
Posts recentes
-

-
 Fisioterapia esportiva dá dinheiro? Veja salários e mercadojunho 26, 2026
Fisioterapia esportiva dá dinheiro? Veja salários e mercadojunho 26, 2026 -
 Vale a pena fazer pós em fisioterapia cardiorrespiratória?junho 23, 2026
Vale a pena fazer pós em fisioterapia cardiorrespiratória?junho 23, 2026 -

-

-

Conheça os Nossos Cursos
© Todos os direitos reservados
2026 -
Faculdade de Ciências Médicas da Santa Casa de São Paulo.
Desenvolvido por Consultoria Digital
Desenvolvido por Consultoria Digital